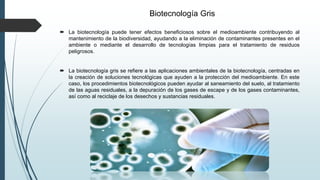
Biotecnología Gris
 La biotecnología puede tener efectos beneficiosos sobre el medioambiente contribuyendo al
mantenimiento de la biodiversidad, ayudando a la eliminación de contaminantes presentes en el
ambiente o mediante el desarrollo de tecnologías limpias para el tratamiento de residuos
peligrosos.
 La biotecnología gris se refiere a las aplicaciones ambientales de la biotecnología, centradas en
la creación de soluciones tecnológicas que ayuden a la protección del medioambiente. En este
caso, los procedimientos biotecnológicos pueden ayudar al saneamiento del suelo, al tratamiento
de las aguas residuales, a la depuración de los gases de escape y de los gases contaminantes,
así como al reciclaje de los desechos y sustancias residuales.

Este documento presenta una investigación sobre los diferentes tipos de biotecnología, incluyendo la biotecnología blanca, verde, azul, gris y naranja. Describe las aplicaciones de cada tipo de biotecnología, como la biotecnología blanca se usa en procesos industriales, la verde en agricultura y alimentos, la azul en ambientes acuáticos, la gris en protección ambiental y la naranja en educación. La conclusión resume que la biotecnología trabaja para aprovechar pro